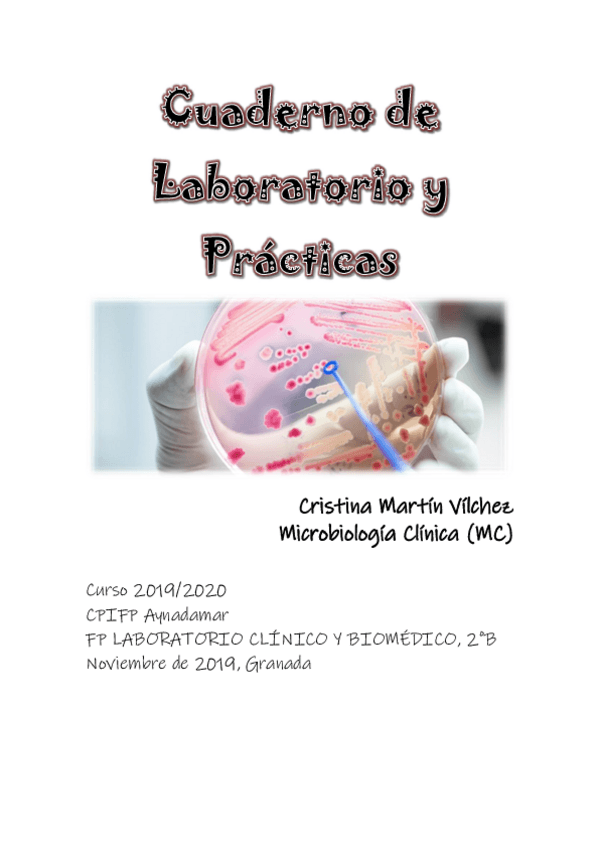

Microbiología clínica
trabajos
-
Trabajos HLC 2ª EVALUACIÓN
He publicado nuevos trabajos de Microbiología clínica: Trabajos HLC 2ª EVALUACIÓN
trabajos
-
Trabajos HLC 1ª EVALUACIÓN
He publicado nuevos trabajos de Microbiología clínica: Trabajos HLC 1ª EVALUACIÓN
practicas
-
Prácticas
He publicado nuevos practicas de Microbiología clínica: Prácticas
trabajos
-
Actividades HLC
He publicado nuevos trabajos de Microbiología clínica: Actividades HLC
practicas
-
practicas microbiología todo el curso
He publicado nuevos practicas de Microbiología clínica: practicas microbiología todo el curso
apuntes
-
Prácticas
He publicado nuevos apuntes de Microbiología clínica: Prácticas
apuntes
-
Actividades y Apuntes
He publicado nuevos apuntes de Microbiología clínica: Actividades y Apuntes
apuntes
-
HLC Cuaderno de Prácticas (micología)
He publicado nuevos apuntes de Microbiología clínica: HLC Cuaderno de Prácticas (micología)
apuntes
-
Resúmenes temas microbiología (no HLC).
He publicado nuevos apuntes de Microbiología clínica: Resúmenes temas microbiología (no HLC).
apuntes
-
actividades micro (HLC)
He publicado nuevos apuntes de Microbiología clínica: actividades micro (HLC)
practicas
-
Prácticas micro 2 trimestre
He publicado nuevos practicas de Microbiología clínica: Prácticas micro 2 trimestre
practicas
-
Prácticas micro
He publicado nuevos practicas de Microbiología clínica: Prácticas micro
He publicado nuevos ejercicios de Microbiología clínica: Actividades-micologia-I.pdf
apuntes
-
PRÁCTICAS PRIMER TRIMESTRE
He publicado nuevos apuntes de Microbiología clínica: PRÁCTICAS PRIMER TRIMESTRE
He publicado nuevos apuntes de Microbiología clínica: enfermedades-parasitarias.docx
He publicado nuevos apuntes de Microbiología clínica: MEDIOS-DE-CULTIVO.docx
He publicado nuevos ejercicios de Microbiología clínica: Actividades-tema-8.pdf
He publicado nuevos ejercicios de Microbiología clínica: Actividades-parasitologia-2a-parte-1.pdf
He publicado nuevos ejercicios de Microbiología clínica: Parasitologia-1o-parte.pdf
He publicado nuevos ejercicios de Microbiología clínica: Actividades-tema-1-parte-II.pdf
He publicado nuevos ejercicios de Microbiología clínica: Documento-sin-titulo.pdf
He publicado nuevos ejercicios de Microbiología clínica: Actividades-unidad-1-parte-1.pdf

¡Estás al día!
Has visto todos los archivos